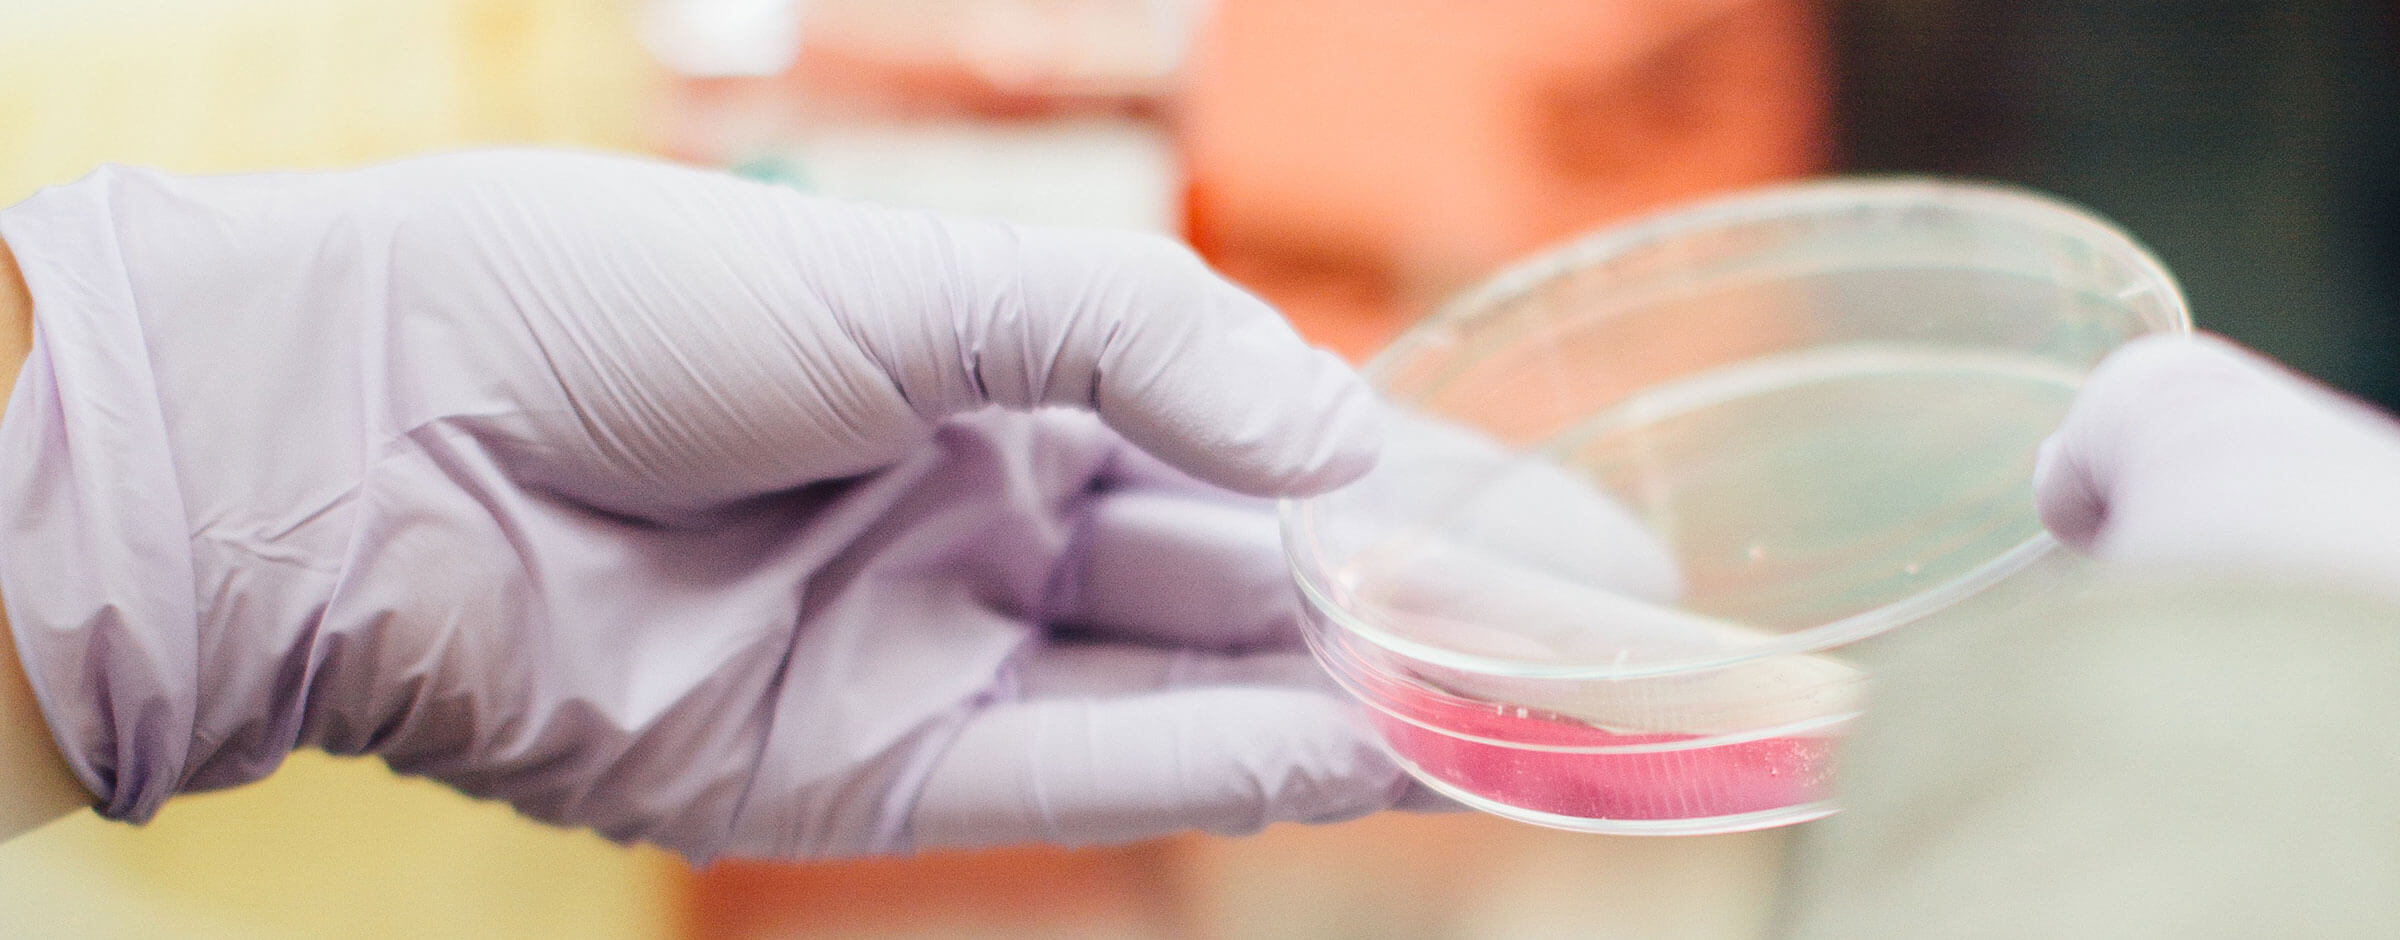
biotecnología alimentación
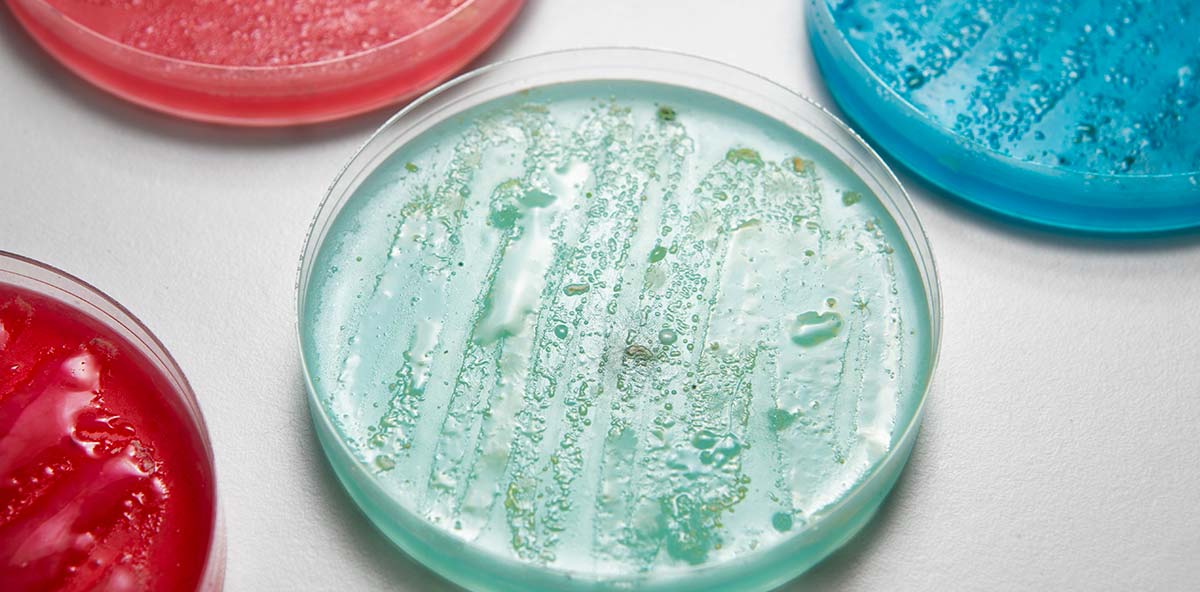
bacterias_marinas_compuestos_bioactivos

Alimentos y productos biotecnológicos
La biodiversidad de nuestros océanos es una de las mayores fuentes de microorganismos y enzimas de interés biotecnológico que permiten el desarrollo de procesos de producción de compuestos de alto valor añadido más sostenibles. Por otro lado, la industria alimentaria genera diversos subproductos que pueden ser utilizados como fuente de nutrientes para la producción de microorganismos de interés comercial (micro algas, hongos) y sus productos derivados, dentro de un concepto de Economía Circular.
Buscamos soluciones para la valorización de los océanos y la innovación en la producción de alimentos
Exploramos la diversidad genética y aislamos microorganismos en nuevos ambientes con el objetivo de identificar vías metabólicas microbianas que participen en la producción de compuestos de interés (omega-3), procesos de biotransformación, y la colonización de superficies inmersas (biofouling).
Índice de contenidos
Biotecnología alimentaria
Innovamos en la obtención de bioproductos naturales a través de la producción de microorganismos a partir de subproductos alimentarios, para la aplicación en la producción de alimentos más sanos, saludables y seguros (tanto para alimentación animal como humana), así como en el desarrollo de procesos industriales más sostenibles y menos contaminantes.
Biotecnología azul
En AZTI exploramos la diversidad genética y funcional de los microorganismos marinos para el desarrollo de nuevas aplicaciones biotecnológicas. Partiendo de aislados bacterianos de diversos nichos marinos o del inmenso repertorio de genes funcionales en las comunidades microbianas naturales, nuestro objetivo es identificar compuestos y procesos de biotransformación de interés para la mejora de la salud humana y la protección del medio ambiente. Algunos de los ejemplos de nuestras líneas de investigación son:
- Identificación de enzimas procesadoras de glicanos marinos con aplicación en los campos de la glicómica y la salud humana
- Identificación de nuevos polisacáridos marinos con potencial bioactivo
- Identificación de nuevos microorganismos marinos productores de ácidos grasos poliinsaturados (Omega-3)
- Utilización de bacterias marinas para la biorremediación de mercurio de sedimentos marinos